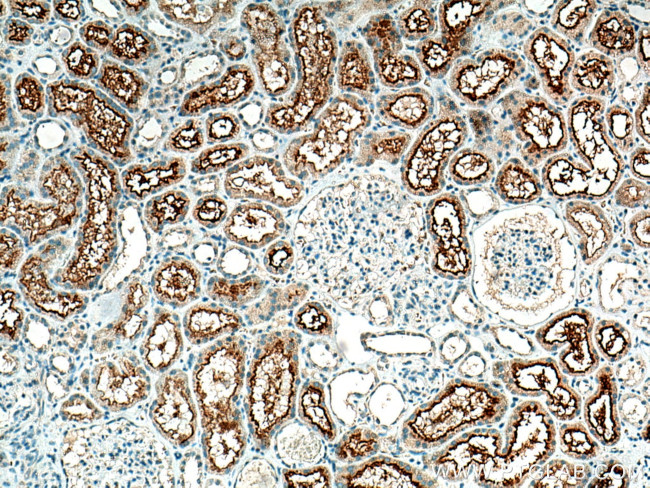
SLCO4C1 Antibody in Immunohistochemistry (Paraffin) (IHC (P))

Search
Proteintech
SLCO4C1 Polyclonal Antibody
{{$productOrderCtrl.translations['antibody.pdp.commerceCard.promotion.promotions']}}
{{$productOrderCtrl.translations['antibody.pdp.commerceCard.promotion.viewpromo']}}
{{$productOrderCtrl.translations['antibody.pdp.commerceCard.promotion.promocode']}}: {{promo.promoCode}} {{promo.promoTitle}} {{promo.promoDescription}}. {{$productOrderCtrl.translations['antibody.pdp.commerceCard.promotion.learnmore']}}
产品信息
24584-1-AP
种属反应
宿主/亚型
分类
类型
抗原
偶联物
形式
浓度
规格
纯化类型
保存液
内含物
保存条件
运输条件
产品详细信息
Immunogen sequence: MKSAKGIEN LAFVPSSPDI LRRLSASPSQ IEVSALSSDP QRENSQPQEL QKPQEPQKSP EPSLPSAPPN VSEEKLRSLS LSEFEEGSYG WRNFHPQCLQ RCNTPG (1-105 aa encoded by B C152989)
靶标信息
Organic anion transporter, capable of transporting pharmacological substances such as digoxin, ouabain, thyroxine, methotrexate and cAMP. May participate in the regulation of membrane transport of ouabain. Involved in the uptake of the dipeptidyl peptidase-4 inhibitor sitagliptin and hence may play a role in its transport into and out of renal proximal tubule cells. May be involved in the first step of the transport pathway of digoxin and various compounds into the urine in the kidney. May be involved in sperm maturation by enabling directed movement of organic anions and compounds within or between cells. This ion- transporting process is important to maintain the strict epididymal homeostasis necessary for sperm maturation. May have a role in secretory functions since seminal vesicle epithelial cells are assumed to secrete proteins involved in decapacitation by modifying surface proteins to facilitate the acquisition of the ability to fertilize the egg.
仅用于科研。不用于诊断过程。未经明确授权不得转售。
生物信息学
蛋白别名: OATP-H; OATP-M1; Oatp-R; OATP4C1; Organic anion transporter M1; Organic anion transporting polypeptide 4C1; SLCO4C1; Solute carrier family 21 member 20; Solute carrier organic anion transporter family member 4C1; unnamed protein product
基因别名: 9530051F04; C330017E21Rik; OATP-H; OATP-M1; oatp-R; OATP4C1; OATPX; PRO2176; SLC21A20; SLCO4C1
UniProt ID: (Human) Q6ZQN7, (Mouse) Q8BGD4
Entrez Gene ID: (Human) 353189, (Mouse) 227394